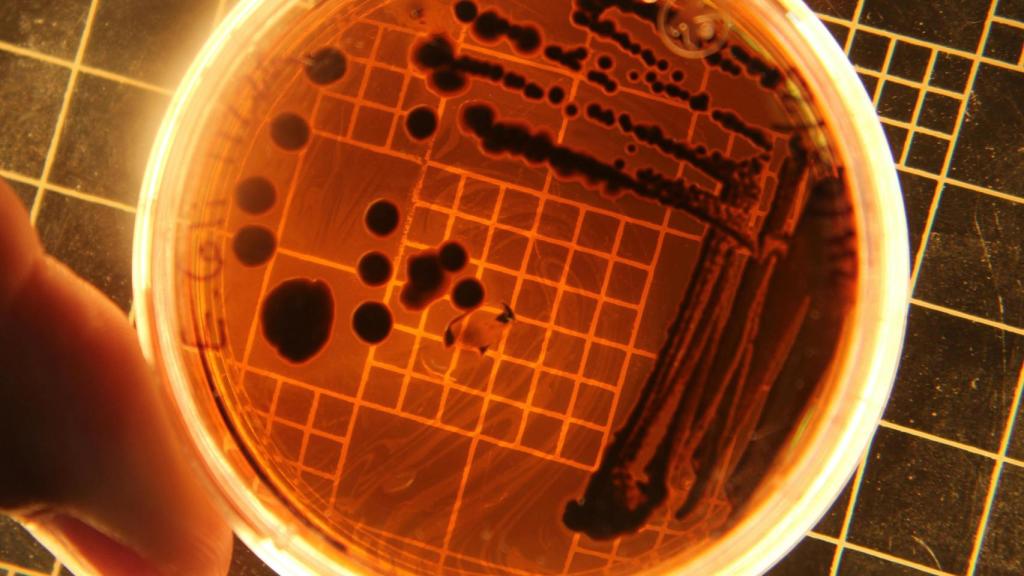
Muestras de E. Coli.

Muestras de E. Coli.
Un estudio relaciona el auge del cáncer de colon en jóvenes con las infecciones por E. Coli sufridas en la infancia
La toxina bacteriana colibactina, producida por cepas de Escherichia coli, puede estar detrás del aumento del cáncer colorrectal de aparición temprana.
Más información: Las bacterias matan ya más gente que el ictus, el alzhéimer o la diabetes: 7,7 millones en todo el mundo
El aumento de los casos de cáncer colorrectal a edades cada vez más tempranas intriga a los médicos de todo el mundo, ya que todavía no se han identificado las causas concretas del fenómeno. Un equipo internacional de investigadores dirigido por científicos de la Universidad de California en San Diego, y en el que ha participado el CNIO desde España, señala ahora como posible culpable a una toxina, la colibactina, producida por algunas cepas de la bacteria Escherichia coli.
Aunque el E.coli es conocida principalmente como contaminante ambiental, algunas cepas benignas forman parte de la microbiota intestinal de los seres humanos. Una exposición temprana en la infancia a la colibactina a causa de una infección, no obstante, se ha relacionado con alteraciones en el ADN de las células del colon que predisponen a sufrir cáncer antes de los 50 años. Los resultados, basados en el análisis de casi un millar de genomas de tumores colorrectales obtenidos de pacientes de 11 países, incluidos españoles, se publican ahora en Nature.
El patrón de mutaciones provocadas por la colibactina era tres veces más frecuente en los pacientes jóvenes, especialmente si habían sufrido cáncer antes de los 40 años, en comparación con los diagnosticados a partir de los 70. Además, las alteraciones eran más prevalentes en los países con mayor incidencia de casos tempranos, como Argentina, Brasil, Colombia, Rusia o Tailandia.
“El artículo muestra que las firmas mutacionales en el cáncer colorrectal varían entre países, lo que supone una buena evidencia de las diferencias regionales en la exposición ambiental", valora Julian Peto, catedrático de Epidemiología de la London School of Hygiene & Tropical Medicine (Reino Unido), en declaraciones a Science Media Centre. "Sin embargo, no es una prueba concluyente de que el aumento de la exposición a la colibactina sea una causa importante del reciente aumento del cáncer colorrectal en las generaciones nacidas desde 1950".
No obstante, el investigador principal Ludmil Alexandrov, profesor de Departamento de Medicina Celular y Molecular, y del Departamento de Bioingeniería de la UC San Diego, sostiene que adquirir las mutaciones provocadas por la colibactina con 10 años puede implicar un adelanto del cáncer. "Pueden ir décadas por delante, desarrollando tumores colorrectales a los 40 años cuando los habrían sufrido a los 60", explica. La bacteria colonizaría silenciosamente a los niños, alterando molecularmente su ADN y precipitando la carcinogénesis.
Los estudios previos, incluidos los realizados en el laboratorio de Alexandrov, identificaron estas mutaciones mediadas por la colibactina en hasta el 15% de todos los casos de cáncer colorrectal. Sin embargo, este estudio es el primero que determina su concentración particular en los tumores tempranos. Las implicaciones son determinantes, sostiene el investigador, ya que la incidencia en pacientes jóvenes se ha duplicado en los últimos 20 años. Para 2030, se habrá convertido en la primera causa de muerte por cáncer en menores de 50 años.
Poseer este nuevo biomarcador puede ayudar a la prevención, ya que los factores de riesgo en jóvenes son inespecíficos -obesidad e hipertensión- y se ha sospechado desde hace años del efecto de alguna exposición microbiana o ambiental. "Nuestro objetivo original era examinar los patrones globales de cáncer colorrectal para entender por qué algunos países tienen tasas mucho más altas que otros", explica Marcos Díaz-Gay, del CNIO.
"Pero a medida que lo analizábamos, el hallazgo más interesante y llamativo fue la frecuencia con la que las mutaciones relacionadas con la colibactina aparecían en los casos tempranos", prosigue. Según los análisis, estas alteraciones se adquieren en los primeros 10 años de vida, y tienen un papel precursor de la formación del tumor. Y serían responsables del 15% de las mutaciones en el gen APC, que aumenta el riesgo de sufrir cáncer.




